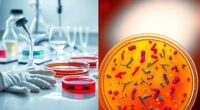

To manage pH fluctuations in hydroponics effectively, consider using automatic pH controllers for continuous monitoring and precise adjustments. Incorporate high-quality pH buffers and regular testing with reliable meters to catch deviations early. Use RO water or conditioners to reduce mineral content and prevent unstable shifts. Maintain system cleanliness and carefully manage nutrient additions to avoid sudden pH swings. Implementing these advanced techniques helps stabilize pH, promoting healthy growth—keep exploring to learn more about optimizing your system.
Key Takeaways
- Implement automatic pH controllers for continuous real-time monitoring and precise adjustments.
- Use high-quality pH buffers and supplements combined with regular testing for rapid correction.
- Maintain water quality with reverse osmosis filtration and system cleaning to prevent mineral buildup.
- Pre-mix nutrients with water, then test and adjust pH to avoid sudden fluctuations during feeding.
- Calibrate pH meters regularly and employ narrow-range pH controllers to ensure system stability.

Maintaining a stable pH level is crucial for ideal system performance, especially when pH fluctuations can disrupt processes or harm equipment. When your hydroponic system’s pH drifts out of the optimal range, it can cause nutrient lock, where plants struggle to absorb vital nutrients. This not only stunts growth but also jeopardizes root health, making your plants more susceptible to disease and stress. To prevent this, you need advanced stabilization techniques that keep pH steady and guarantee your plants thrive.
Stable pH is essential to prevent nutrient lock and ensure healthy plant growth.
One of the most effective methods is using high-quality pH buffers and supplements that act quickly to correct deviations. Regularly testing your water with a reliable pH meter is critical; don’t rely solely on test strips, as they can be less precise. When you detect a shift, promptly add the appropriate pH adjusters—either acids or bases—to bring the level back into the ideal range. This rapid response minimizes the risk of nutrient lock and keeps your roots healthy.
Incorporate automatic pH controllers into your system for continuous monitoring and adjustment. These devices can be calibrated to maintain a narrow pH window, reducing manual intervention and human error. By automating pH stabilization, you create a more consistent environment that supports optimal nutrient uptake and root development. Consistency is key because even minor fluctuations can have cumulative negative effects over time.
Furthermore, managing the quality of your water source plays a significant role. Hard water, with high mineral content, can cause pH swings that are harder to control. Using reverse osmosis (RO) filtration or water conditioners can reduce mineral levels, leading to more stable pH levels. Keep in mind that organic matter and residues can also influence pH, so regular cleaning and maintenance of your system are necessary to prevent buildup that could cause instability.
Additionally, understanding how sound vibrations influence cellular regeneration and overall health can inspire complementary practices that support plant resilience. Lastly, pay close attention to your nutrient formulations. Some nutrients are pH-sensitive and can shift the system’s pH when added. Pre-mixing nutrients with water and testing pH after each addition helps you understand their impact and avoid sudden fluctuations. Consistent, deliberate adjustments and vigilant monitoring are your best strategies to prevent nutrient lock and safeguard root health, ensuring your hydroponic system functions efficiently and your plants reach their full potential.

Automatic pH Controller with Dosing Pump & Dual Relay Output for pH Up and Down Dispense, Wall Mounted Aquariums pH Temperature Monitor with Data Chart Display for Hydroponic Nutrient Reservoir
PH UP AND DOWN CONTROLLER: Landtek digital ph controller equiped with dosing pumps for ph level measurement and…
As an affiliate, we earn on qualifying purchases.
As an affiliate, we earn on qualifying purchases.
Frequently Asked Questions
How Do Ph Fluctuations Affect Nutrient Uptake Efficiency?
Ph fluctuations directly impact your plants’ nutrient absorption and root health. When pH levels shift, nutrients become less available, leading to deficiencies. You might notice slower growth or weak roots. To keep nutrient uptake efficient, it’s essential to maintain stable pH levels. Consistent pH control ensures your roots stay healthy and can absorb nutrients effectively, promoting vigorous growth and maximizing your hydroponic system’s productivity.
What Are the Signs of Ph Instability in Hydroponic Systems?
Imagine your system as a delicate dance where pH instability throws off the rhythm. You’ll notice pH shock, where levels suddenly spike or drop, causing stress. Nutrient lockout may follow, leaving plants starved despite abundant nutrients. Signs include slowed growth, wilting, or discoloration. These clues signal pH instability, urging you to stabilize your solution swiftly to prevent further imbalance and keep your plants thriving.
Can Ph Stabilization Methods Vary for Different Plant Species?
Yes, pH stabilization methods can vary for different plant species. You should make plant-specific adjustments because each species has unique nutrient requirements and pH tolerance levels. Species-based stabilization guarantees ideal growth by tailoring pH levels to individual plants’ needs. By understanding these differences, you can implement targeted pH control strategies, leading to healthier plants and better yields in your hydroponic system.
How Often Should Ph Levels Be Monitored During Growth Cycles?
You should monitor pH levels at least once daily during growth cycles to guarantee ideal plant health. Regular testing frequency helps catch fluctuations early, preventing nutrient lockout. Always calibrate your sensors regularly for accurate readings, ideally before each testing session. This proactive approach allows you to make timely adjustments, maintaining stable pH levels and promoting vigorous growth. Consistent monitoring and calibration are key to successful hydroponic cultivation.
Are There Environmentally Friendly Ph Correction Options Available?
Imagine you’re adjusting pH naturally in your hydroponic system; organic amendments like seaweed extract can help stabilize pH levels gently. Biological solutions, such as beneficial microbes, also improve nutrient uptake and buffer pH fluctuations. These eco-friendly options reduce chemical use, making your grow more sustainable. By integrating organic amendments and biological solutions, you create a healthier environment for your plants while minimizing environmental impact.

Digital pH Tester for Water, pH Meter for Hydroponic Water, TDS Tester EC PPM Test for Plant Nutrients, 4-in-1 Meter for Conductivity, pH Pen for Drinking Water, DWC, Indoor Plants
Multi-functional 4-in-1 pH Tester: Our GIDIGI digital pH testers are versatile and can measure not only pH values…
As an affiliate, we earn on qualifying purchases.
As an affiliate, we earn on qualifying purchases.
Conclusion
You might think pH swings are just minor nuisances, but they can unexpectedly disrupt your entire hydroponic system. By mastering advanced stabilization techniques, you’ll find that maintaining ideal pH becomes second nature—almost like a lucky coincidence. When your pH stays steady, your plants thrive effortlessly, and you’ll wonder how you ever managed without these strategies. It’s a surprising twist that simple adjustments can lead to remarkable growth—proving that precision truly pays off in hydroponics.

Biopharm pH Calibration Buffer 2-Pack, 500 mL (1.06 Pint) Each: pH 4.00 and pH 7.00; NIST Traceable Reference Standards for All pH Meters
Color Coded for Easy Identification
As an affiliate, we earn on qualifying purchases.
As an affiliate, we earn on qualifying purchases.

Aquatic Life RO Buddie 3-Stage Hydroponic Reverse Osmosis Water Filter System RO Filtration Unit, 75 GPD
CONVENIENT RO WATER – The AquaticLife RO Buddie is a 3-stage RO reverse osmosis system designed for hydroponic…
As an affiliate, we earn on qualifying purchases.
As an affiliate, we earn on qualifying purchases.